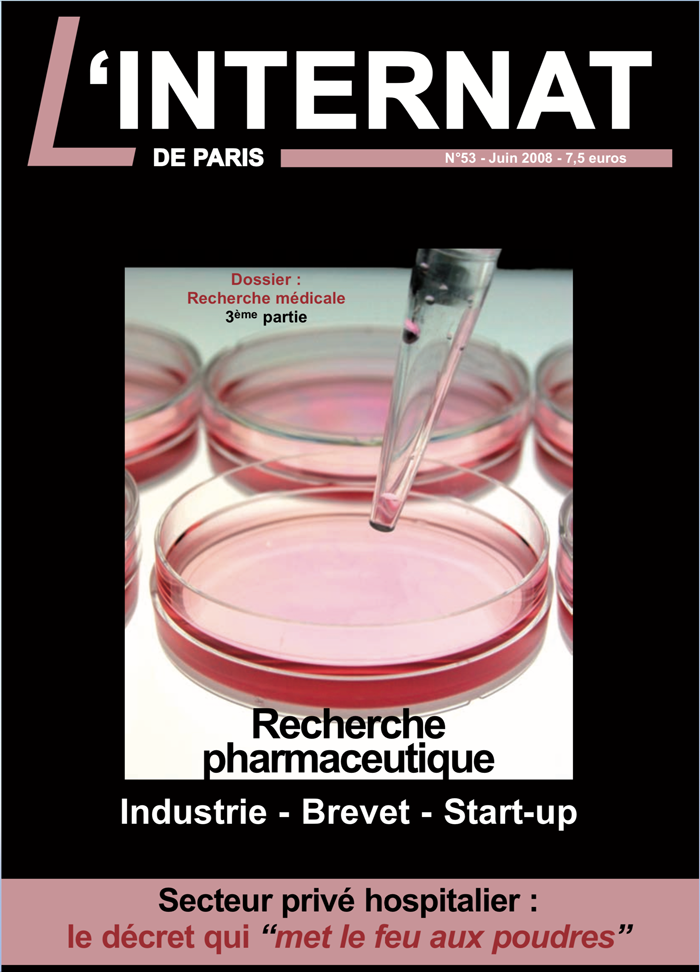

- Cardiologie
- Chirurgie
- Chirurgie Cardio Vasculaire
- Chirurgie Orthopédique et Traumatologique
- Dermatologie
- Diabétologie
- Endocrinologie, diabète et maladies métaboliques
- Endocrinologie, diabétologie, nutrition
- Gynécologie
- Gynécologie obstétrique
- Hémophilie
- Hépato - Gastroentérologie
- Immunologie
- Infectiologie
- Médecine interne

L'internat de Paris est la revue trimestriel des médecins spécialistes issus du concours de l’Internat des hôpitaux de Paris et quelque soit leur mode d’exercice et leur stade de carrière. En toute indépendance, édité par l'AAIHP qui regroupe à sa tête des Professeurs de grande renommée, ses rédacteurs en chef entretiennent des rapports privilégiés avec les institutions du milieux de la Santé, tant au niveau français qu’au niveau européen. De nombreux grands médecins, pour la plupart KOL (Key Opinion Leader) participent au fil des numéros à la réussite de ce projet en conjuguant savoir et pédagogie, afin de confier leurs interprétations sur les innovations constantes du monde de la santé d’aujourd’hui. La complémentarité qu’introduit la "notion de réseau de l'AIHP" au sein de la revue, depuis maintenant plus d'une décennie, sous la houlette du Professeur Emmanuel Chartier-Kastler, AIHP 84, lui confère une crédibilité intellectuelle notoire. Une ligne éditoriale critique et engagée en toute indépendance a fait gagner en notoriété une revue aujourd’hui reconnue auprès d’un public avide de recul et d’actualité de ces disciplines à la fois si différentes et complémentaires.
Dernière revue parue
N° 117

Edito dossier lithiase urinaire
Olivier TRAXER
Analyse morpho constitutionnelle et reconnaissance endoscopique des calculs
Vincent ESTRADE
La chirurgie percutanée en France : évolutions, indications, innovations
Charles GAILLARD - Nadia ABID
La LEC après 45 ans d’expérience : où en sommes-nous ?
Chrisophe ALMERAS
Pulvérisation LASER des calculs urinaires : différentes technologies et leurs résultats
Olivier TRAXER - Frédéric PANTHIER
Diététique et lithiase rénale : tout est dans l’assiette !
Olivier TRAXER - Marie-Lou LETOUCHE
Médicaments de la lithiase urinaire
Valentine FORTÉ - Jean-Philippe HAYMANN